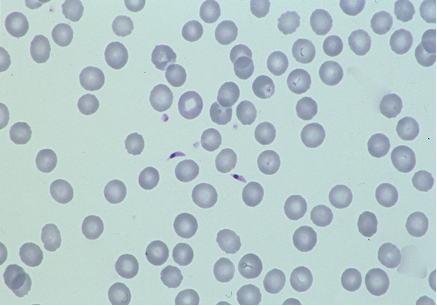

Impact Factor ISSN: 1449-1907
Int J Med Sci 2009; 6(3):120-122. doi:10.7150/ijms.6.120 This issue Cite
Short Communication
Introduction into Pathology of Ocular Zoonoses
Institute of Pathology - University of Freiburg im Breisgau (Germany)
Published 2009-3-19
Zoonosis: what does it mean?
The meaning of the term “Zoonosis” has changed greatly over the time. At least in the first half of the 19th century, early microscopes easily identified fungi, small animals, protozoans and metazoans: bacteria and viruses were much too small to be visualized. Hence, for more than a century, the term zoonosis indicated any disorder due to infectious agents visible by microscope. Ironically, the first reports of cytomegaly were attributed to an infection by a novel fungal or amebic organism. However, with the advent of modern microbiolgy the understanding of zoonosis has changed completely. No later than 1958, the World Health Organization produced an official definition of Zoonosis as: “diseases transmitted in a natural way from vertebrate animals to humans”. Currently, three subtypes of Zoonoses may be distinguished: [1]
- Zooanthroponoses: transmitted from vertebrates to humans.
- Anthropozoonoses (rare): transmitted from humans to animals.
- Geonoses/Sapronoses: diseases produced by animal-borne infectious agents, surviving in faeces, food, soil, or on plants, from there eventually affecting humans.
- treatise on ocular Zoonoses will be divided into two main groups A and B, according to their respective way of transmission.
A. Zoonoses transmitted through the conjunctiva = the eye is the entrance for the infectious agent
A. 1. Bacterial agents
Parinaud's Syndrome (PS)
PS is probably the first description of an infection by Listeria monocytogenes. It takes its name from the French ophthalmologist, Henri Parinaud, who, in 1889, described a granulomatous conjunctivitis with regional suppurative lymphadenitis and parotid oedema, mainly affecting butchers, stable-hands, and coachmen. Tthe infection is transmitted after contamination of hands with animal faeces.
Cat Scratch Disease (CSD)
CSD was also described by a French ophthalmologist, Debré, in 1950. Its etiological agent is the gram-negative bacterium, Bartonella henselae, responsible for a specific type of lymphadenitis with microabscesses bordered by reticulo-histiocytic cells (Figure 1) and hyperplastic conjunctivitis, with regional lymph node swelling, fever and anorexia. Prognosis is usually favourable, but in 2% of cases, arthritis, encephalitis, optic neuritis and amaurosis may ensue.
Specific lymphadenitis of cat scratch disease. Serial sections stained for Giemsa (left) and chloroacetate esterase (right) at low (top) and high (bottom) magnifications display multiple microabscesses containing densely packed neutrophil granulocytes stained red by the chloroacetate-esterase reaction; abscesses being demarcated against lymphoid tissue by a rim of clear reticulohistiocytic cells.

Conjunctivitis due to Chlamydia psittaci (CP)
CP mainly affects guinea pigs, or cats or birds, and may be transmitted to humans directly through the conjunctiva from pet animals. CP causes a keratitis punctata superficialis with intracellular reticular bodies and follicular conjunctivitis. The infection is typically chronic and may induce a chronic antigenic stimulation of the lymphoid ocular adnexal tissue - the so called OA MALT (Ocular Adnexal Mucosa -Associated Lymphoid Tissue). As has been shown recently by the Milanese group of Ferreri and co-workers, chronic chlamydial conjunctivitis may induce a low malignant MALT-lymphoma. [2]
B. Zoonoses transmitted to the eye via blood
B. 1. Protozoan agents
Toxoplasma gondii (TG)
Primary gastrointestinal infestation with oocysts from feline faeces or intake of raw/undercooked meat from diverse animals with intracellular cysts containing asexually spawned bradizoits, leads to a haematogeneous spread of TG. Any organ may get infected. During acute infection, groups of tachycoites multiply rapidly within intracellular cysts. The immune response induces the formation of bradycoites tightly packed in larger cysts containing hundreds of organisms. In case of self-limited toxoplasmosis, lymph nodes display transitorily a specific lymphadenitis type Piringer-Kuchinka. Immune deficiency (AIDS) leads to severe progressive disease often terminating with hemorrhagic necrotizing encephalitis and sometimes with copious extracellular toxoplasms freely present in blood smear (Fig. 2). As a chronic disease, toxoplasmosis may persist with intraocular lesions even in cases of a resolved general infection.
Toxoplasmosis in late stage AIDS with two extracellular toxoplasms in the central part of the blood smear. We owe this extraordinary observation to Pr. Dr. Maria-Thérèse Daniel, Hôpital Saint Louis, Paris.
B. 2. Helminthic agents
Helminthic organisms of vertebrate animals may infect humans, who represent a sort of “accidental host”. These helminths may cause cysticercosis and larva migrans syndrome and dirofilariasis.
Cysticercosis
Cysticercosis is an infection by the larval stage of the type worm Taenia solium. Ocular symptoms are the consequence of cystic larval growth and inflammatory reaction due to eventual necrosis of parasites. - Analogous intraocular lesions may be caused by coenuriasis, the larval stage of tape worms of the genus Multiceps. Definitive hosts are dogs and wolves.
Larva migrans visceralis syndrome
Nematodes which are common intestinal ascarids in dogs (Toxarara canis), cats (T. cati), racoons (Baylisascaris) or pigs (Ascaris suum) may infect man, leading to an abnormal migration of larval stages The vagrant larvae enter the circulatory system, may locate in any organ, die and provoke various inflammatory reactions, the “Larva migrans syndrome” presenting with a broad spectrum of anorexia, eosinophilia, fever, muscle and joint pains and petit mal seizures.
Larva migrans ophthalmica syndrome
Totally independent from the presence and intensity of larva migrans visceralis, a single larva coming to the eye may reach the ocular fundus causing severe chronic endophthalmitis with retinal detachment.
Filariasis
Adult filarial nematodes infest different regions of the human body, in a way which is specific for each species. The genus Dirofilaria is of only marginal interest for the eye. Dogs (D. immitis) and other mammals, including cat, fox, wolf, otter, raccon (D. tenuis), and sea lion serve as common hosts. From those natural hosts microfilariae circulating in blood may accidentally be transmitted by mosquitoes to man. Larvae migrate, produce local inflammation and die in various stages of development. This may cause thrombotic lesions in the heart (D. immitis), fibronecrotic spherical coin lesions in the lungs, in lymph nodes, in the subcutis and in the conjunctiva (D. repens, D. tenuis,“D. conjunctivae”) and later a granulomatous reaction. Lesions may go unnoticed and in endemic areas up to 20% of the population is seropositive. However in delicate organs like the eye, infection is more easily noticed, hence ocular infestation is the most evident.
References
1. Kraus H, Weber A, Appel M, Enders B, Graevenitz A, Isenberg HD, Schiefer HG, Slenczka W, Zahner H. Zoonosen. Von Tier zu Mensch übertragbare Infektionskrankheiten. Auflage. Deutscher Ärzte-Verlag, Köln. 2004
2. Ferreri AJ, Guidoboni M, Ponzoni M, De Conciliis C, Dell'Oro S, Fleischhauer K, Caggiari L, Lettini AA, Dal Cin E, Ieri R, Freschi M, Villa E, Boiocchi M, Dolcetti R. Evidence for an association between Chlamydia psittaci and ocular adnexal lymphomas. J Natl Cancer Inst. 2004;96:586-594

 Global reach, higher impact
Global reach, higher impact